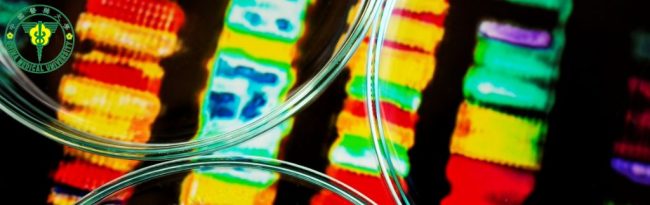
Population-Specific Genomic Data Improves Disease Risk Prediction in the Taiwanese Han Population

Environmental Plastic Exposure May Promote Early-Onset Breast Cancer Through Metabolic Changes
Post Views: 114 Environmental Plastic Exposure May Promote Early-Onset Breast Cancer Through Metabolic Changes Breast cancer diagnosed before the age of 45, often referred to as early-onset breast cancer, tends to be more aggressive and more difficult to treat than cases diagnosed later in life. While inherited mutations in BRCA1 and BRCA2 account for some early cases, a large proportion of patients do not carry…